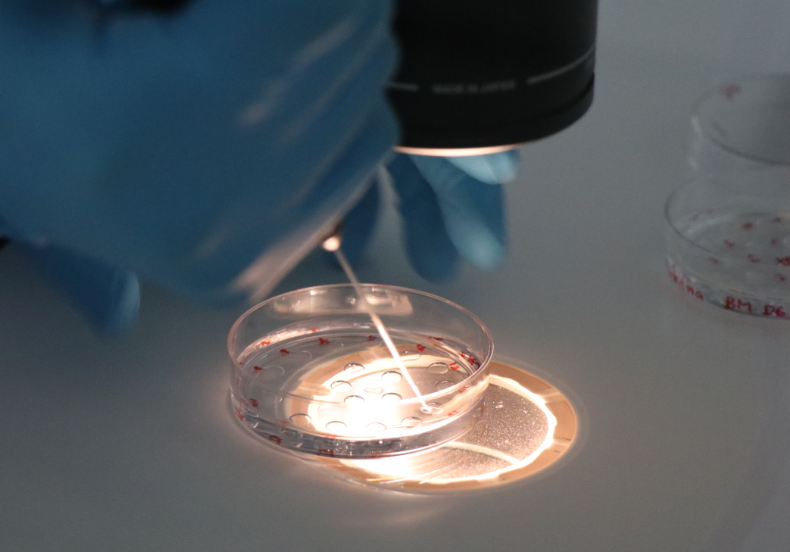

最近人们对生育问题的关注也越来越高。而对于一些不孕不育患者来说,三代试管技术成为了他们解决生育问题的重要手段。南京鼓楼医院是一家集医疗、教学、科研为一体的三级甲等综合性医院,也是示范性单位。那么南京鼓楼医院三代试管怎么样呢?
南京鼓楼医院三代试管技术优势
南京鼓楼医院作为国内有名的医疗机构,其生殖医学中心的三代试管技术备受赞誉。以下是南京鼓楼医院三代试管技术的优势:
1.高成功率:南京鼓楼医院生殖医学中心经过多年的发展和积累,已经具备了较高的试管成功率。在三代试管技术方面,该中心已经形成了成熟的技术体系,为不孕不育患者提供了较高的成功率。
2.安全可靠:南京鼓楼医院生殖医学中心在试管技术方面具备了丰富的经验和专业知识,为患者提供安全可靠的服务。在三代试管技术中,该中心会对胚胎进行基因检测,确保胚胎不存在遗传性疾病,从而保证母婴健康。
3.适应症广:南京鼓楼医院的三代试管技术适用于多种不孕不育症。例如,对于高龄妇女、子宫内膜异位症、多囊卵巢综合症等患者,该中心能够通过三代试管技术为其提供有效的治疗手段,帮助患者实现生育梦想。
4.优质服务:南京鼓楼医院生殖医学中心拥有一支专业的医疗团队和先进的医疗设备,能够为患者提供全方位、个性化的服务。从前期检查到治疗方案制定,再到胚胎移植等各个环节,该中心都会为患者提供专业、细致的服务。
5.经验丰富:南京鼓楼医院生殖医学中心拥有丰富的试管技术经验,已经为众多不孕不育患者成功实现了生育梦想。同时,该中心还不断开展新技术研究和实践,不断提升试管技术的安全性和成功率。
南京鼓楼医院作为一家值得信赖的选择,在三代试管领域得到了广泛认可,并且具有很高水平和优势特色。如果您需要进行三代试管操作,请放心选择南京鼓楼医院!
*图文内容仅供学习参考,不能作为诊断依据,个体有差异,如有不适请前往正规医院就诊!

上海
重庆
北京
天津